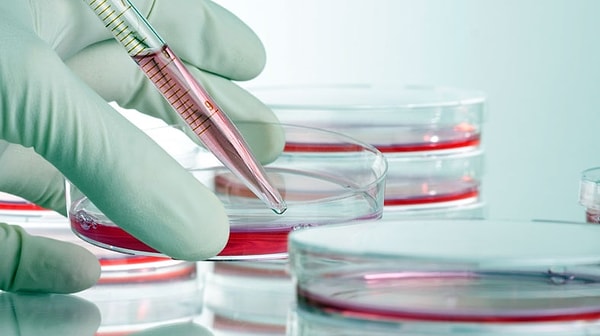
17. Ученые использовали стволовые клетки в борьбе с опухолью головного мозга.

Важные события в науке и медицине с начала 2015 года
Основное время своего эфира многие передачи уделяют политике и экономике. Но в мире происходят не менее важные события в сфере науки и медицины. Мы выбрали для вас важные события, произошедшие с начала 2015 года.
1. Ученые смогли уничтожить ВИЧ.

В отличие от исследований по контролю и уменьшению вреда ВИЧ, ученым впервые удалось полностью удалить вирус из клеток.
2. Череп изготовленный при помощи трехмерного принтера удалось пересадить человеку.

22-летней женщине из Нидерландов удалось пересадить верхнюю часть черепа, сделанную на трехмерном принтере. В связи с хроническим заболеванием костей, толщина ее черепа достигла 5 см. Она жаловалась на головные боли и теряла зрение.
3. Впервые в истории медицины удалось пересадить остановившееся сердце.

Австралийским докторам удалось пересадить остановившееся сердце и вернуть к жизни пациента.
4. Женщина с пересаженной маткой родила ребенка.

Очередное открытие в сфере медицины произошло в Швеции. Женщина с пересаженной маткой родила ребенка.
В результате операции, которая прошла во главе Мэтса Брэннсторм (Mats Brannstrom) - доктора Гетеборгского Университета, 36-летней женщине удалось совершить это чудо.
5. В лабораторных условиях вырастили функциональный орган.

Английские ученые впервые в условиях лаборатории вырастили орган, который выполняет все функции.
6. Ученые нашли бактерии, которые поедают раковые клетки.

В результате исследований ученые нашли бактерии, которые питаются раковыми клетками и уменьшают опухоль.
7. Мариам Мирзахани стала первой женщиной в истории, которая получила Филдсовскую премию.

Родившаяся в Иране Мариям Мирзахани стала первой женщиной в истории, которая получила Филдсовскую премию за «Выдающийся вклад в динамику и геометрию римановых поверхностей и теорию пространств их модулей».
8. Американские ученые разработали самозаряжающуюся батарейку.

Американские исследователи объявили, что они разработали первую самозаряжающуюся батарейку. Она переходит в химическую реакцию с водой и воздухом. Поэтому ее называют «дышащей батарейкой».
9. Создали искусственную кожу.

Ученым удалось вырастить искусственную кожу в условиях лаборатории. Главная цель - использование этой кожи в тестах для лекарств и косметики вместо животных.
10. Создали мышцы, которые могут сами себя восстанавливать.

Ученым удалось разработать мышцы, которые самостоятельно восстанавливаются.
11. Ученые разработали технологию, которая производит искусственные вены.

Специалисты Общества Фраунгофера разработали технологию, которая позволяет производить искусственные вены, используя для этого специальный принтер.
12. Искусственному интеллекту удалось пройти Тест Тьюринга

Искусственный интеллект под именем Женя Густман, согласно первоначальным сообщениям в СМИ, впервые сумел пройти тест Тьюринга, который был разработан английским математиком и криптографом.
13. Впервые удалось запечатлить застывшую воду на планете Меркурий.

Космический корабль под названием MESSENGER отправил снимки застывшей воды на ближайшей к Солнцу планете. Следы льда были сняты на северном полюсе Меркурия.
14. Произведена невидимая солнечная панель.

Американским ученым удалось разработать почти прозрачную солнечную панель.
15. Ученые усилили память при помощи электричества.

Американские ученые смогли увеличить человеческую память при помощи электричества, которое они подали в определенные части мозга.
16. На земле провели эксперимент сверхновой вспышки.

Ученым удалось создать сверхновую вспышку в условиях лаборатории. Она известна как самая сильная вспышка во вселенной. Искусственная вспышка так же создала волны с заряженными частицами.
17. Ученые использовали стволовые клетки в борьбе с опухолью головного мозга.
В долгосрочном процессе это стало надеждой в борьбе с опухолью головного мозга.
18. Началось строительство самого большого телескопа

В Чили провели церемонию запуска строительства самого большого в мире телескопа.
19. Разработан электрокардиостимулятор размером меньше, чем зерно риса.

Разработанный электрокардиостимулятор размером меньше, чем зерно риса, удалось зарядить при помощи наружного зарядного устройства размером с кредитную карточку. Этим способом американские ученые сделали очередное открытие в области науки и медицины.
20. Разработана роботизированная рука, которой мысленно можно управлять.

Роботизированная рука, разработанная одной американской компанией, была одобрена Управлением по Санитарному Надзору за Качеством Пищевых Продуктов и Медикаментов Америки. Рука, которая может выполнять разные функции, будет отличным решением.
21. Перепрограммированные клетки впервые были пересажены человеку.

Японцы впервые пересадили клетки iPS (перепрограммированные клетки) человеку.
22. Произведен аппарат, который ставит диагноз кровоизлияния в мозг.

При помощи нового аппарата легко и надежно можно поставить диагноз кровоизлияния в мозг.
Keşfet ile ziyaret ettiğin tüm kategorileri tek akışta gör!

Напишите комментарий